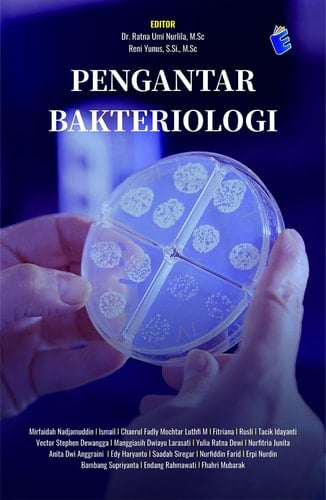
Pengantar Bakteriologi

Buku pengantar bakteriologi yang berada ditangan pembaca ini terdiri dari 18 bab. Pembahasan pada setiap bab nya diuraikan dengan bahasa yang sederhana dengan harapan agar pembaca mudah dalam memahaminya. Bab 1 Klasifikasi Bakteri Bab 2 Morfologi, Struktur, dan Fisiologi Bakteri Bab 3 Distribusi dan Peran Bakteri Bab 4 Isolasi dan Identifikasi Bakteri Bab 5 Genetika Bakteri Bab 6 Nutrisi Bakteri Bab 7 Metabolisme Bakteri Bab 8 Mikroflora Normal Bab 9 Bakteri Patogen Gram (+) Kokus Bab 10 Bakteri Patogen Gram (+) Batang Bab 11 Bakteri Patogen Gram (–) Kokus Bab 12 Bakteri Patogen Gram (–) Batang Bab 13 Pengendalian Bakteri (Sterilisasi, Desinfeksi, Antibiotika) Bab 14 Pewarnaan Bakteri Bab 15 Biakan Murni Bab 16 Uji Biokimia Bakteri Bab 17 Uji Sensitivitas Bakteri Bab 18 Jaminan Mutu Pemeriksaan Bakteriologi
Page Count:
322
Publication Date:
2023-12-04
ISBN-10:
623151952X
ISBN-13:
9786231519528
No comments yet. Be the first to share your thoughts!